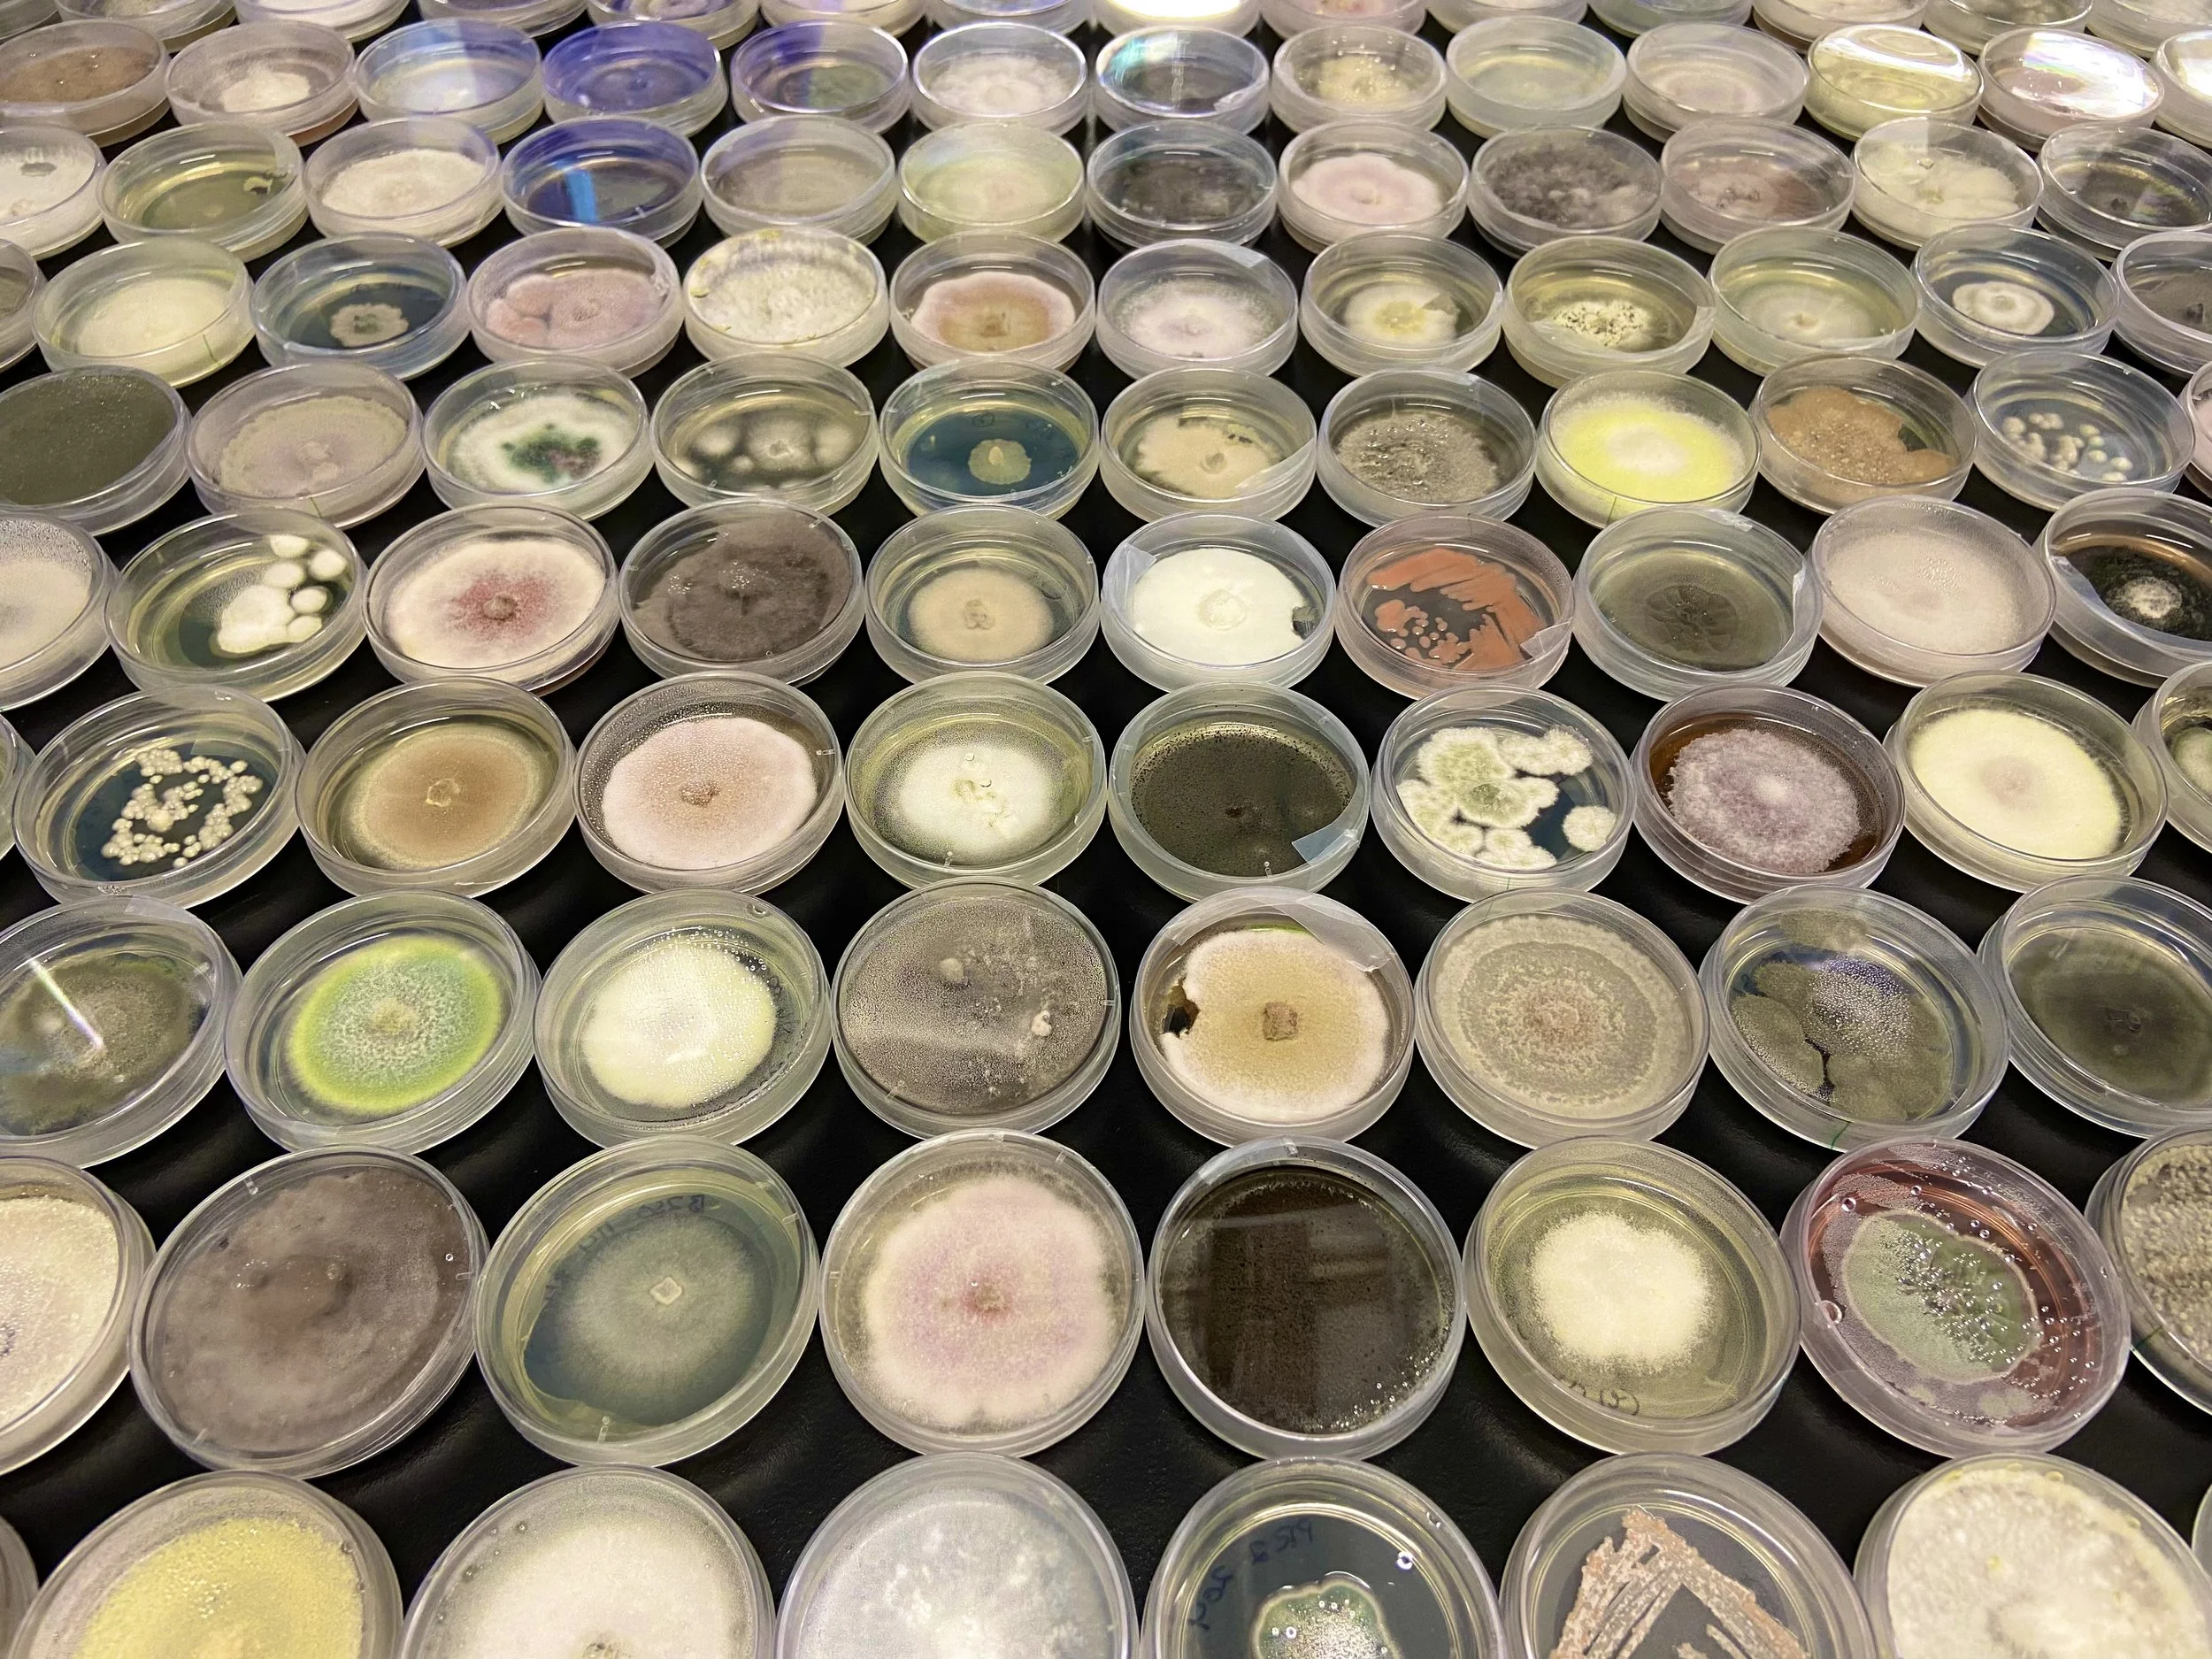
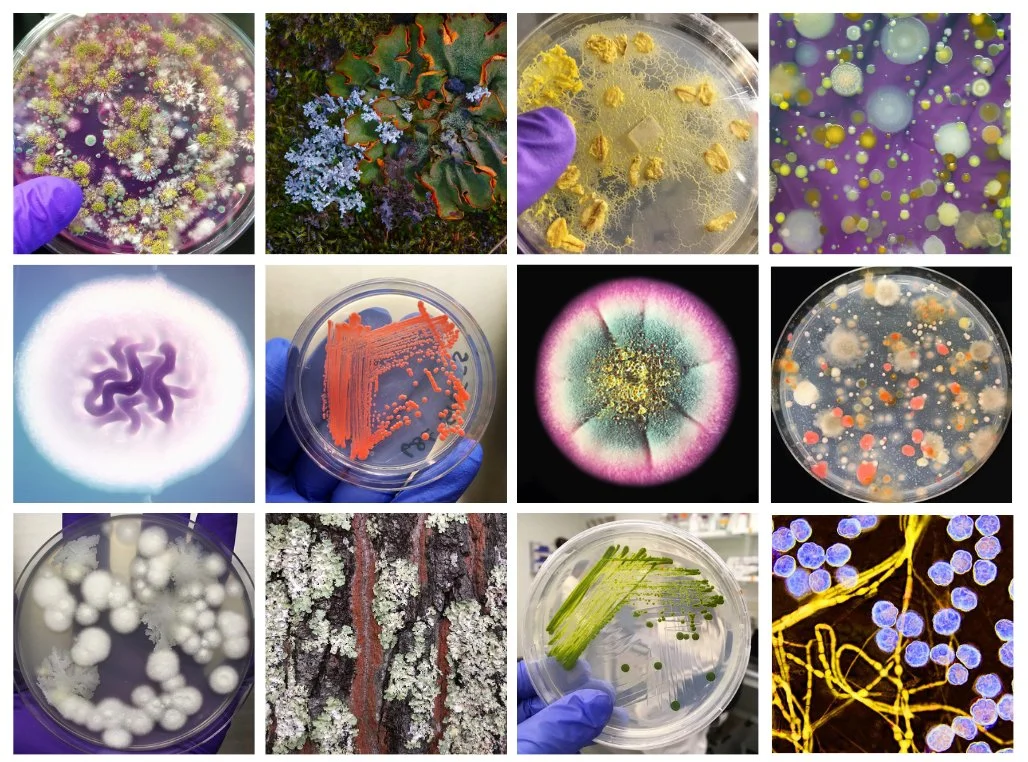

Microbes and Mushrooms: Nature’s Artistry in Detail
A science, art, and education exhibit at The Museum of Beadwork
An Introduction to the Microbial Cosmos

Too often, microbes are thought of as nothing more than germs, agents of disease. Meanwhile, these tiny alchemists are busy breaking down pollutants, synthesizing psychedelic substances, or crafting some of our favorite fermented beverages! The Museum of Beadwork and the Microbe Institute want to change the way we think about the invisible lifeforms who share this planet with us (and who vastly outnumber us).
As part of a truly remarkable–and GLITTERY–participatory science, art, and education experience to open in 2026 at the Museum of Beadwork in Portland, Maine, we’re asking you to help us reveal this unseen world through the use of beadwork. To learn more about the call for new art, the associated science education special exhibit and workshops, and the opening date of the new exhibit, please visit the link below. To help inspire you to create such art, we’ve provided a brief intro, and collection of resources on this page to welcome you to the microbial cosmos.

Microbes (and Mushrooms): The Basics
Microorganisms, or 'microbes,' include bacteria, fungi, protists and viruses. They are a group of creatures that are so small that we often need a microscope to see them. The smallest and most basic unit of all living things is a cell. Microbes can be just one cell or have many cells (multicellular).* Even with one cell, microbes can eat, drink, excrete waste, grow and reproduce.
Microbes come in various shapes and sizes—some are spheres, while others are hot dog-shaped. Some look like long strings. Some microbial species can even move around and change their shape. Most microbes divide asexually, which means one cell divides into two to make new and more microbes. Depending on the microbe species and where they live, they can reproduce in 20 minutes, or take decades to replicate.
Mushrooms are a fungus. They are the fruiting bodies—reproductive structures—produced by certain fungal species. While some fungi produce mushrooms, others live their lives as nearly invisible cells.
* Viruses, unlike other microbes, are not made from cells and require host cells to reproduce.

Microbes can live almost anywhere. They are present in clouds, in dust particles floating in air, in water, in the deep floors of the ocean, in soil, food, and plants. They’re even in our dishwashers and washing machines. They live on you and in you. They are everywhere!
They are also extremely diverse. For example, there are more microbial species in our backyard soil than there are species of animals or plants in this world. Only a very tiny minority of all microbial species cause disease or are harmful to humans. Most microbial species are either harmless or helpful to us. Today, scientists use microbes to help crops grow, to clean up pollution, and to produce many of our life-saving medications. (Photo credits: Smith and Nasht, A. Madden, and T. Debenport)

For visual inspiration and more information, check out the slideshow and links below!



A quick video about how microbes improve our lives
A TED talk by Dr. Anne A. Madden

For visual inspiration
Glamor shots of fungi and bacteria at different scales by scientist and artist Tracy Debenport (@under.the.scope)

For visual inspiration
A gallery of Scanning Electron Micrographs of microbes

Learn more about how microbes grow
Visit our Kitchen Microbial Art activity to learn how microbes replicate on Petri dishes (and how you can paint with yeast!)

An interview about how microbes improve our lives
An NPR TED Radiohour Interview with Dr. Anne A. Madden

For visual inspiration
Captivating microbial photography by scientist and artist Dr. Scott Chimileski.

For a documentary on fungi
A documentary on fungi, featuring The Microbe Institute’s Founder, Dr. Anne A. Madden

Visit a website to learn more about microbes
“Interbiota” is an education portal created by one of our science-art fellows

A free activity book on how microbes improve our lives
Made with Microbes is a free art and activity book that highlights a few of the hard-working microbes that benefit humanity in industry, medicine, and food production.

For visual inspiration
Beautiful images of microscopic algae

For more reading…
We recommend the following books: Roberto Kolter and Scott Chimileski’s Life at the Edge of Sight, Ed Yong’s I Contain Multitudes, Merlin Sheldrake’s Entangled Life, and Rob Dunn’s The WildLife of Our Bodies.

Learn about how lichens are microbial partnerships
Visit our Lichen Adventure to learn about how these remarkable partnerships make for strong—and surprisingly beautiful—communities.
For more participatory microbial research, art, and education activities, check out some of our other projects and recent events! Events & More resources.